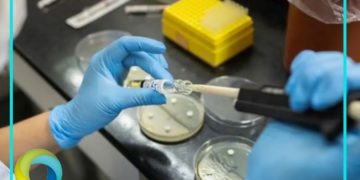

Autoridades mexicanas informaron este viernes, sobre la localización de tres cuerpos hallados en una zona cercana al lugar donde el lunes fueron reportados como desaparecidos dos turistas australianos y un estadounidense, en Baja California, dijeron a Reuters dos fuentes cercanas al caso.
De acuerdo con los reportes de las fuentes, los tres cadáveres fueron localizados en la zona de Santo Tomás, en el municipio de Ensenada del estado Baja California, fronterizo con Estados Unidos.
“El operativo comenzó por la mañana, eran los tres cuerpos”, dijo a Reuters una fuente que prefirió no ser nombrada debido a no tener autorización. “Bomberos estaban ayudando a la extracción de los cadáveres de un pozo“, dijeron sin dar más detalles.
Cabe agregar que la fiscalía de Baja California informó que fue encontrado esta semana un vehículo que coincidía con las características del que utilizaron los turistas durante su recorrido; esto luego de que la semana pasada, familiares de los hermanos australianos Callum y Jake Robinson hicieran público en redes sociales la desaparición de los jóvenes.
La fiscalía estatal informó que autoridades de Australia y Estados Unidos habían sido notificados sobre el caso.

Sé el primero en comentar